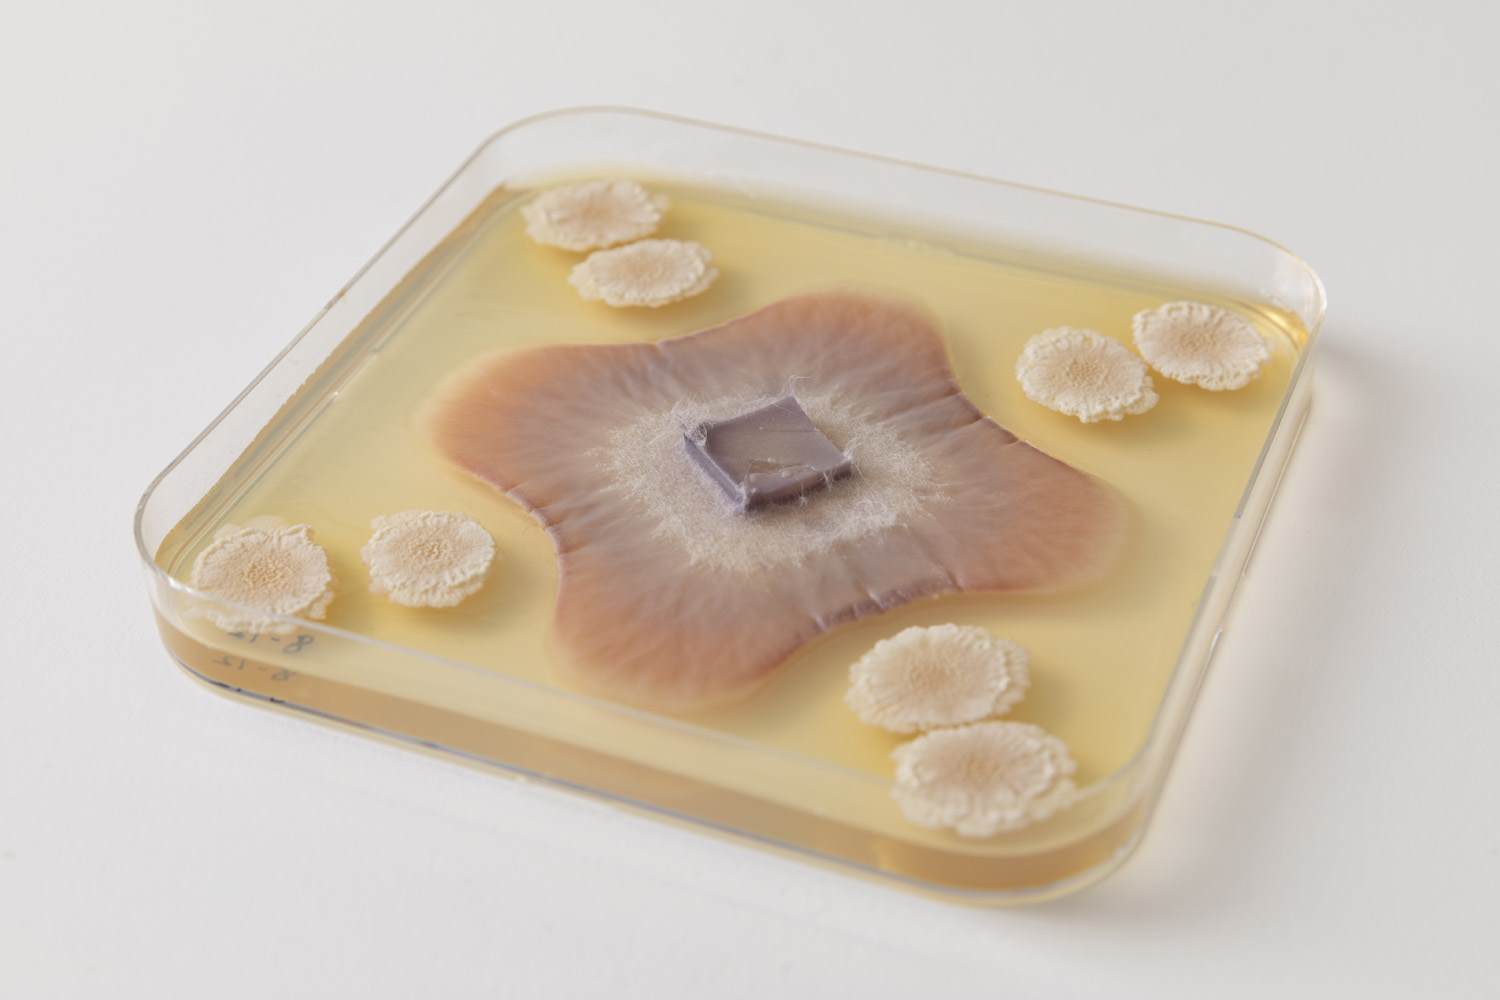
fungi in a petri dish

Agri-sector code of conduct for plastics
The main topic of our March 2025 newsletter updating you on microplastics and the seed industry is the new code of conduct for the agri-sector which was recently issued by the FAO. In addition, you will find the answers to three questions that are often asked about our microplastic-free products.
CONTENTS
- The new FAO code of conduct for the Agri-sector
- Are Incotec MPF products safe for bacteria?
- How long can MPF coatings be stored?
- Do pellets and encrustments also contain microplastics?
FAO Code of conduct
We normally only talk about microplastics here. But let’s focus on plastics in general for a bit. Plastic is used abundantly within our sector. And there are many benefits. To name a few: they play a crucial role in increased productivity, extended growing seasons, reduced water consumption, and reduced use of pesticides and fertilizers. On the other hand, once abandoned, lost, or discarded in the environment, plastics may pose significant risks to the environment and people. Only a small portion of plastic products used in agriculture is collected and recycled worldwide. This happens primarily in developed countries. The FAO has recently developed a Voluntary Code of Conduct on the Sustainable Use and Management of Plastics in Agriculture (VCoC). It’s aim is to provide voluntary guidance for all agricultural sub-sectors, taking into account the need to secure sustainable agrifood systems around the globe. The code can be found here: VCoC
3 question often asked about our MPF products
1. Are Incotec MPF products safe for bacteria?
Compatibility between film coatings and microorganisms is influenced by various factors, but it does not inherently depend on the presence or absence of microplastics.
Microbial diversity is tremendous, and specific microbes need specific conditions to thrive and survive. Different species within the same family, as well as different strains of the same species, can react differently to a product. Therefore, compatibility should be targeted during product development selecting all components of the product. It should always be checked before use and tailor-made solutions are recommended.
2. How long can MPF coatings be stored?
For MPF coatings, we typically guarantee a shelf life of 2 years, provided the material was stored under recommended conditions and in a closed container. This is similar to the shelf life of previous generations of film coats. The fact that all ingredients are microplastic free does not impact the use or storability of our products. At Incotec we employ several methods to ensure that ingredients do not degrade in the container and that coatings can be remixed within the 2-year shelf-life period without adverse effects on application or seed properties.
The coating applied to the seed will retain its properties just as well as the previous generation film coats did. When seeds are stored correctly, there are no adverse effects of the MPF film coats or loss of properties like dust-off or flowability.
When seeds are stored correctly, there are no adverse effects
3. Do pellets and encrustments also contain microplastics?
Some do and some don’t. Pellet materials and their properties are carefully designed and tested to facilitate unhindered germination. This is challenging since the layer around the seed can be quite big and pellets are easily 10 to 40 times heavier than the seed they protect. The impact of changes in the pelleting material recipe can be much more substantial than that of film coats which are only applied in thin layers. Changes to microplastic-free materials means that we must thoroughly validate every step of pellet production. The build-up of the pellet in the pelleting pan, drying of the pellets, and their splitting behaviour once they are sown are all influenced by even the smallest changes in the recipe. After a long and careful process of development, Incotec will be launching several MPF pellets and encrustments in 2025. They will have MPF alternatives for every item in their portfolio in 2026 so that customers have sufficient time to validate the performance and seed safety.

Interdiction des microplastiques : position de l'ISF et de l'industrie semencière